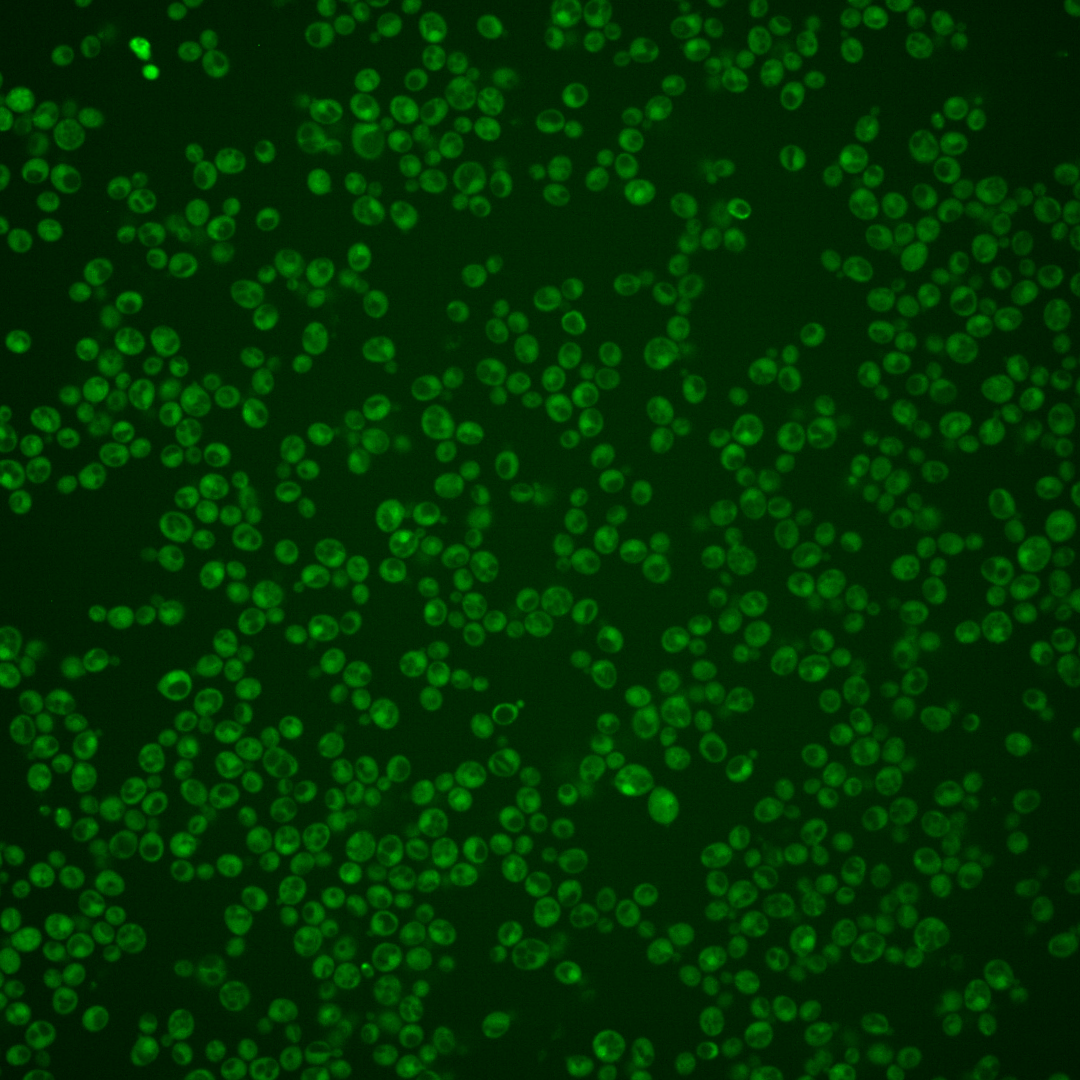
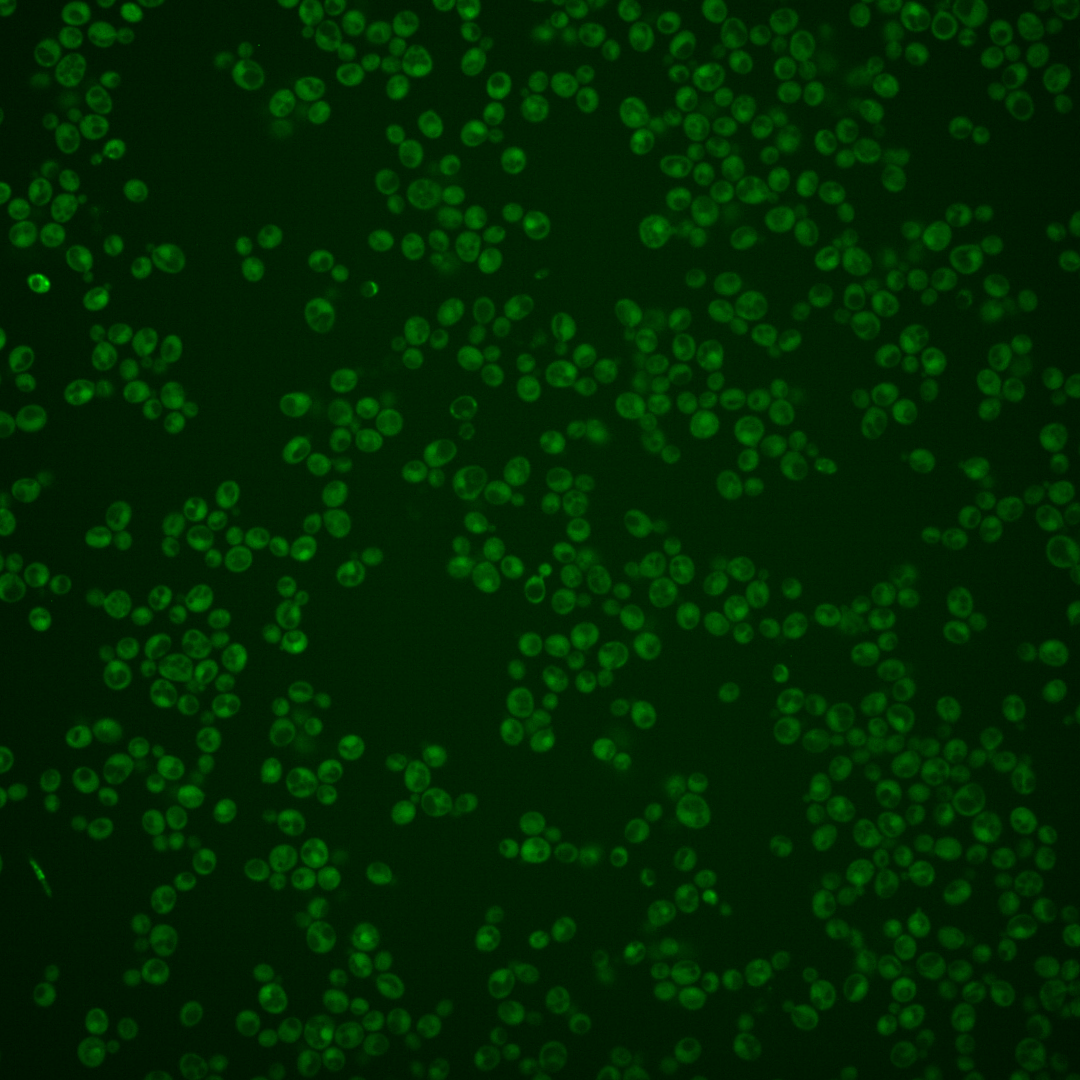
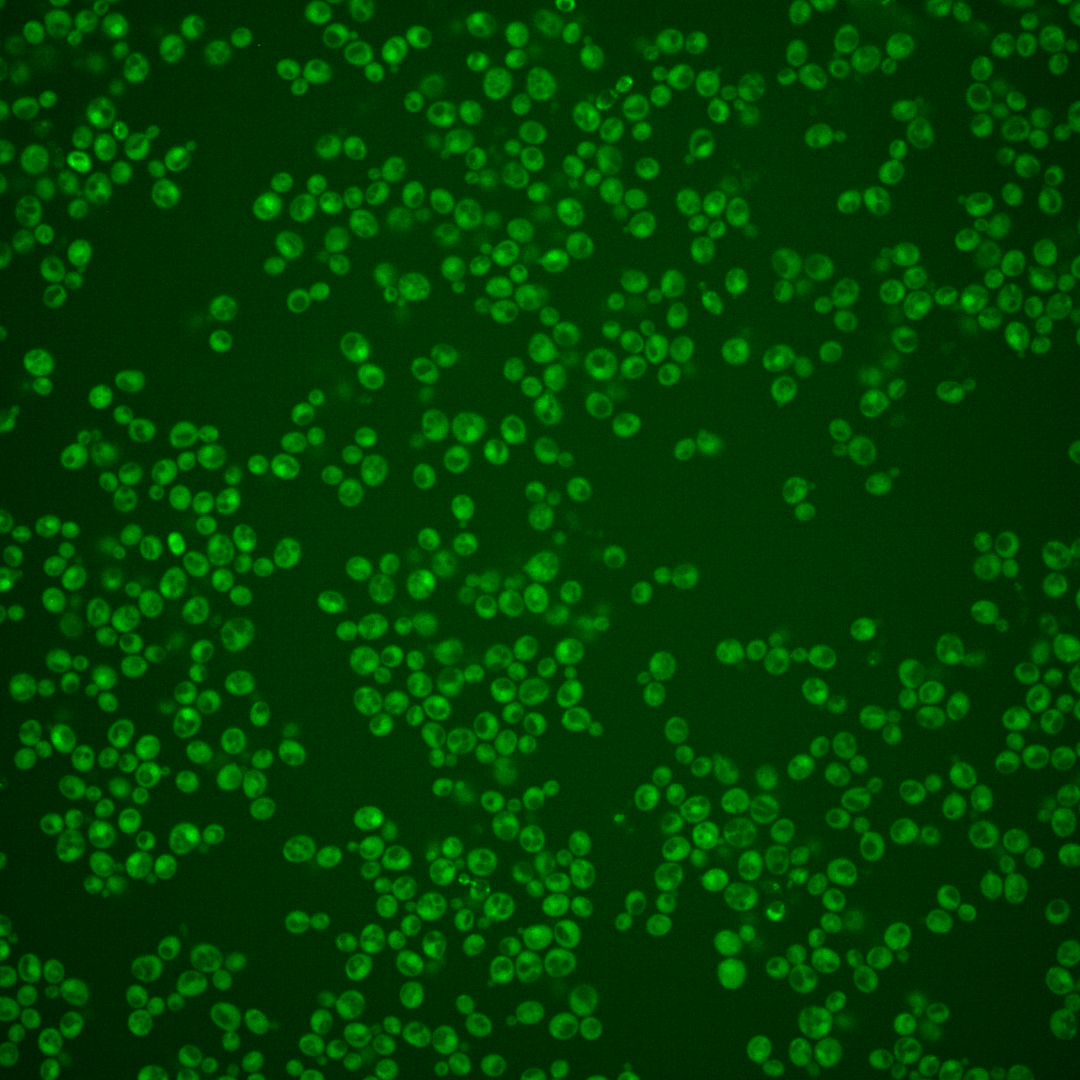
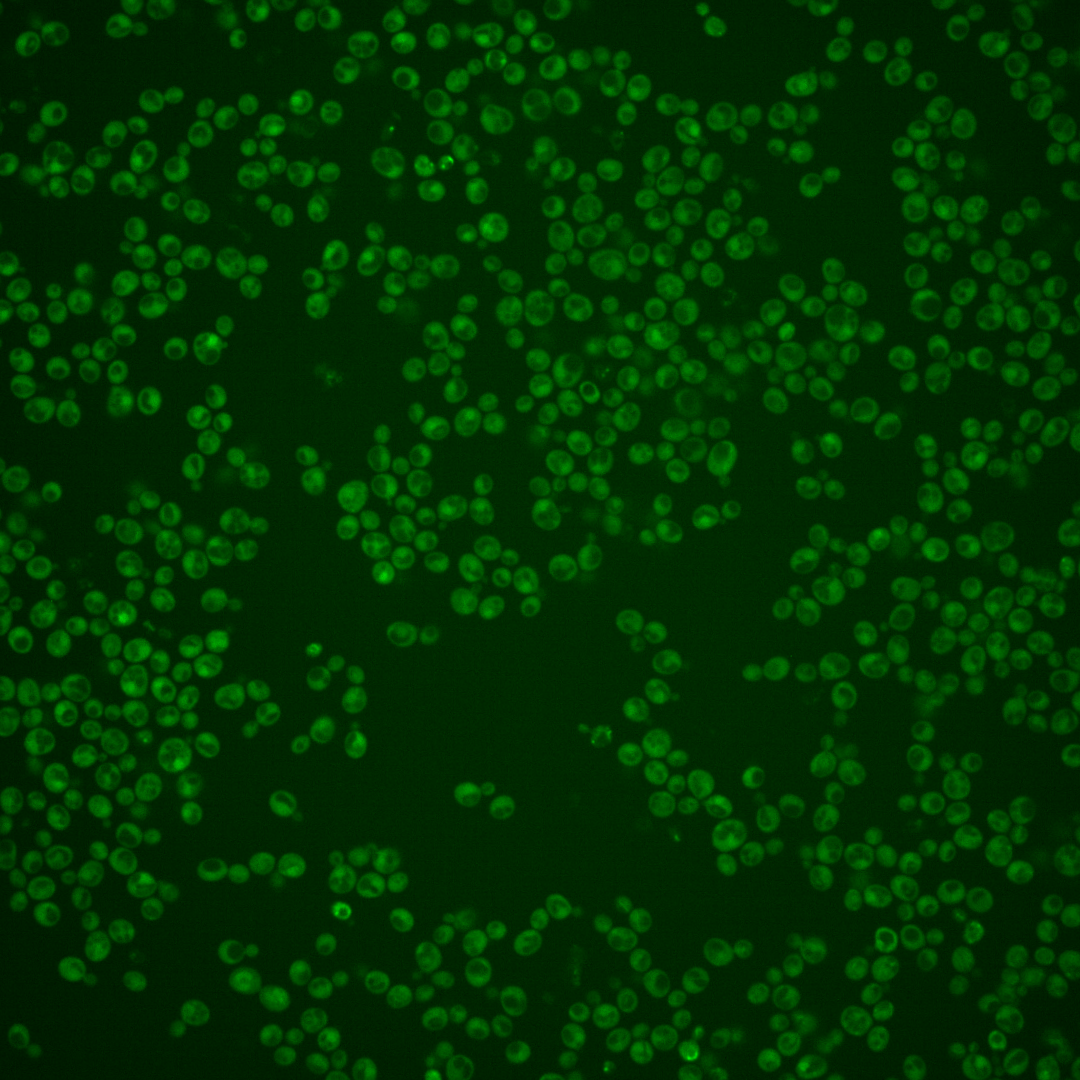
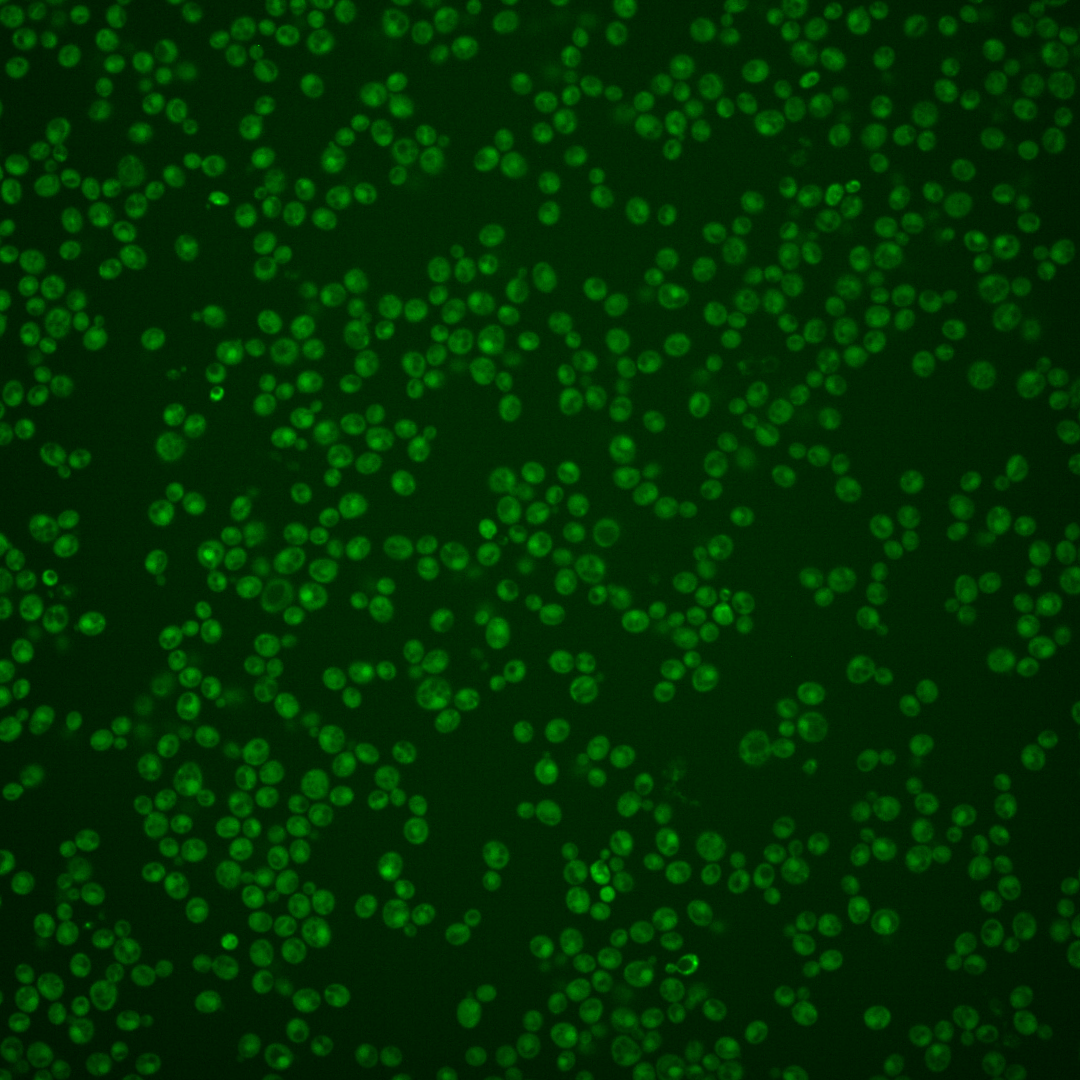
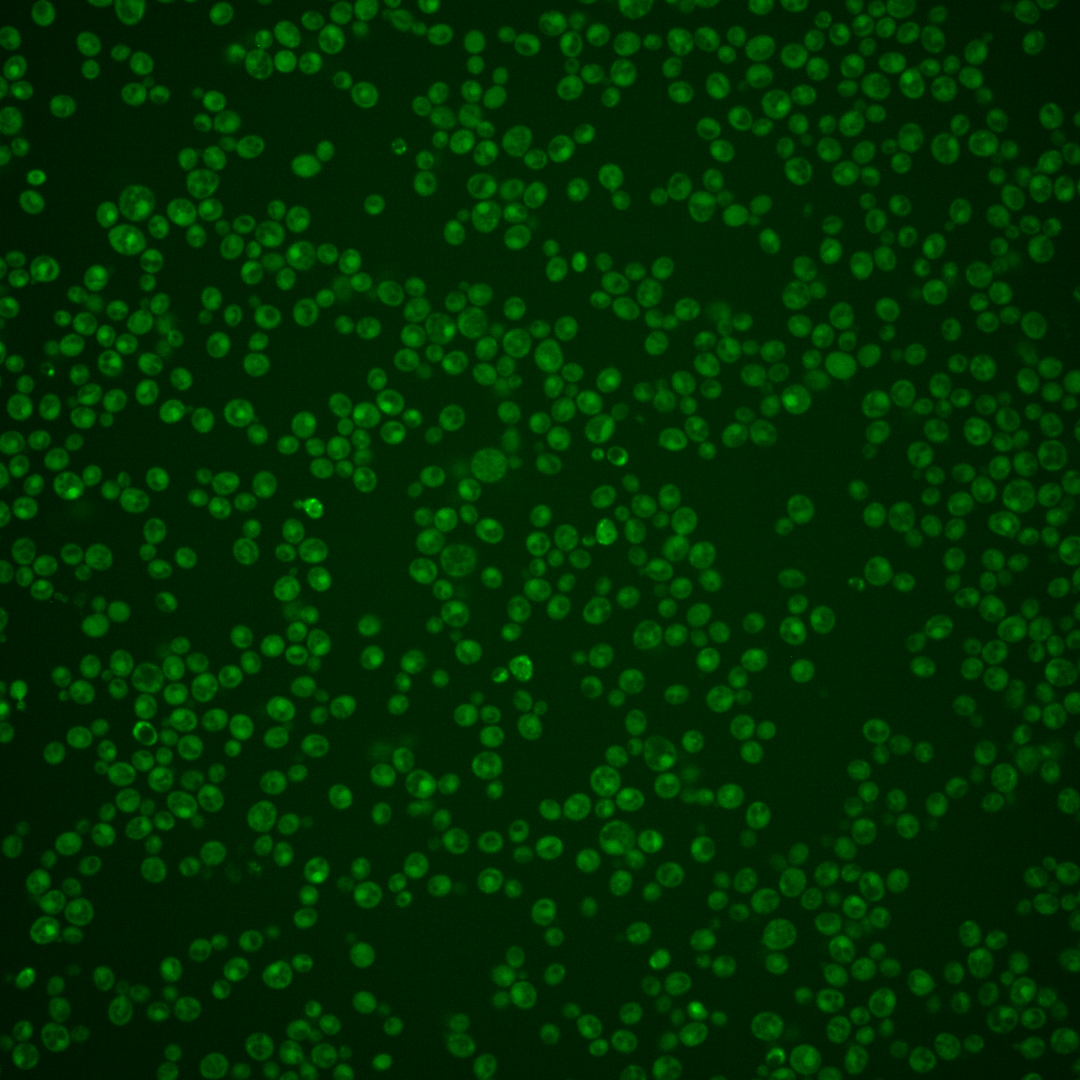

| Standard name | |
|---|---|
| Human Ortholog | |
| Description | G1 cyclin involved in regulation of the cell cycle; activates Cdc28p kinase to promote the G1 to S phase transition; late G1 specific expression depends on transcription factor complexes, MBF (Swi6p-Mbp1p) and SBF (Swi6p-Swi4p); CLN2 has a paralog, CLN1, that arose from the whole genome duplication; cell cycle arrest phenotype of the cln1 cln2 cln3 triple null mutant is complemented by any of human cyclins CCNA2, CCNB1, CCNC, CCND1, or CCNE1 |
Micrographs




















































































Sub-cellular Localization
Yeast GFP Assignment
Protein Abundance
Localization Change
External localization resources
| ensLOC | DeepLoc | |||||||||||||||||||||||
|---|---|---|---|---|---|---|---|---|---|---|---|---|---|---|---|---|---|---|---|---|---|---|---|---|
| Localization | WT1 | WT2 | WT3 | RAP60 | RAP140 | RAP220 | RAP300 | RAP380 | RAP460 | RAP540 | RAP620 | RAP700 | HU80 | HU120 | HU160 | rpd3Δ_1 | rpd3Δ_2 | rpd3Δ_3 | WT1 | WT2 | WT3 | AF100 | AF140 | AF180 |
| Cortical Patches | 0 | 0 | 0 | 0 | 0 | 0 | 0 | 0 | 0 | 0 | 0 | 0 | 0 | 0 | 0 | 0 | 0 | 0 | 3 | 3 | 9 | 2 | 6 | 5 |
| Bud | 2 | 1 | 2 | 3 | 0 | 7 | 11 | 11 | 10 | 17 | 10 | 5 | 1 | 0 | 0 | 1 | 0 | 0 | 5 | 11 | 9 | 4 | 12 | 15 |
| Bud Neck | 1 | 1 | 1 | 0 | 0 | 2 | 1 | 6 | 2 | 4 | 1 | 2 | 1 | 0 | 0 | 6 | 2 | 0 | 1 | 3 | 4 | 2 | 4 | 7 |
| Bud Site | 0 | 1 | 0 | 0 | 0 | 0 | 0 | 1 | 2 | 1 | 1 | 2 | 0 | 0 | 0 | 0 | 0 | 0 | – | – | – | – | – | – |
| Cell Periphery | 4 | 2 | 4 | 1 | 2 | 0 | 3 | 1 | 1 | 3 | 1 | 4 | 1 | 1 | 1 | 1 | 4 | 1 | 0 | 0 | 7 | 1 | 5 | 5 |
| Cytoplasm | 208 | 246 | 385 | 238 | 280 | 353 | 426 | 477 | 301 | 273 | 189 | 171 | 410 | 464 | 462 | 297 | 226 | 161 | 206 | 209 | 264 | 217 | 332 | 257 |
| Endoplasmic Reticulum | 0 | 4 | 0 | 0 | 1 | 1 | 1 | 1 | 1 | 3 | 1 | 1 | 1 | 0 | 0 | 27 | 19 | 11 | 4 | 0 | 3 | 0 | 1 | 3 |
| Endosome | 6 | 0 | 2 | 0 | 2 | 3 | 3 | 2 | 1 | 1 | 0 | 0 | 0 | 2 | 0 | 4 | 3 | 3 | 2 | 2 | 5 | 5 | 3 | 4 |
| Golgi | 0 | 0 | 0 | 0 | 1 | 0 | 0 | 0 | 0 | 0 | 0 | 0 | 0 | 0 | 2 | 1 | 2 | 2 | 2 | 2 | 1 | 2 | 1 | 3 |
| Mitochondria | 36 | 6 | 9 | 41 | 40 | 255 | 284 | 310 | 354 | 384 | 238 | 279 | 0 | 1 | 0 | 19 | 2 | 4 | 24 | 18 | 71 | 12 | 23 | 17 |
| Nucleus | 4 | 2 | 1 | 0 | 0 | 2 | 4 | 4 | 4 | 0 | 2 | 3 | 1 | 1 | 1 | 4 | 7 | 3 | 13 | 18 | 5 | 0 | 0 | 0 |
| Nuclear Periphery | 1 | 0 | 0 | 0 | 0 | 0 | 0 | 1 | 1 | 2 | 1 | 0 | 0 | 0 | 0 | 0 | 0 | 0 | 1 | 0 | 1 | 0 | 0 | 0 |
| Nucleolus | 3 | 1 | 0 | 0 | 0 | 1 | 1 | 1 | 0 | 1 | 1 | 0 | 0 | 1 | 1 | 0 | 0 | 0 | 1 | 0 | 0 | 0 | 0 | 0 |
| Peroxisomes | 0 | 0 | 0 | 0 | 2 | 0 | 0 | 0 | 0 | 0 | 0 | 0 | 0 | 0 | 0 | 0 | 0 | 0 | 0 | 0 | 0 | 0 | 0 | 0 |
| SpindlePole | 2 | 1 | 1 | 1 | 1 | 3 | 12 | 19 | 14 | 4 | 10 | 6 | 0 | 1 | 0 | 1 | 2 | 0 | 12 | 14 | 6 | 5 | 11 | 10 |
| Vac/Vac Membrane | 12 | 30 | 12 | 7 | 4 | 5 | 9 | 9 | 9 | 4 | 2 | 3 | 5 | 1 | 0 | 14 | 16 | 7 | 22 | 14 | 14 | 4 | 6 | 15 |
| Unique Cell Count | 251 | 286 | 405 | 257 | 308 | 508 | 602 | 689 | 543 | 549 | 358 | 372 | 415 | 470 | 464 | 321 | 248 | 171 | 312 | 306 | 420 | 268 | 422 | 359 |
| Labelled Cell Count | 279 | 295 | 417 | 291 | 333 | 632 | 755 | 843 | 700 | 697 | 457 | 476 | 420 | 472 | 467 | 375 | 283 | 192 | 312 | 306 | 420 | 268 | 422 | 359 |
Yeast GFP Assignment
Protein Abundance
| Screen | WT1 | WT2 | WT3 | RAP60 | RAP140 | RAP220 | RAP300 | RAP380 | RAP460 | RAP540 | RAP620 | RAP700 | HU80 | HU120 | HU160 | rpd3Δ_1 | rpd3Δ_2 | rpd3Δ_3 | AF100 | AF140 | AF180 |
|---|---|---|---|---|---|---|---|---|---|---|---|---|---|---|---|---|---|---|---|---|---|
| Mean Cell GFP Intensity (1e-4) | 3.3 | 4.3 | 3.9 | 3.6 | 3.6 | 3.2 | 2.9 | 3.1 | 2.9 | 2.7 | 2.8 | 2.7 | 4.3 | 4.2 | 4.2 | 5.2 | 5.9 | 6.0 | 4.0 | 4.3 | 4.9 |
| Std Deviation (1e-4) | 0.8 | 1.0 | 1.1 | 1.4 | 1.3 | 1.0 | 1.1 | 1.2 | 1.0 | 0.8 | 1.2 | 1.3 | 1.4 | 2.0 | 1.5 | 1.6 | 1.8 | 1.9 | 1.6 | 2.5 | 1.9 |
| Intensity Change (Log2) | – | – | – | -0.13 | -0.12 | -0.31 | -0.46 | -0.34 | -0.45 | -0.55 | -0.46 | -0.55 | 0.12 | 0.12 | 0.09 | 0.42 | 0.58 | 0.61 | 0.02 | 0.14 | 0.32 |
Localization Change
| Localization | RAP60 | RAP140 | RAP220 | RAP300 | RAP380 | RAP460 | RAP540 | RAP620 | RAP700 | HU80 | HU120 | HU160 | rpd3Δ_1 | rpd3Δ_2 | rpd3Δ_3 |
|---|---|---|---|---|---|---|---|---|---|---|---|---|---|---|---|
| Actin | – | – | – | – | – | – | – | – | – | – | – | – | – | – | – |
| Bud | – | – | – | – | – | – | – | – | – | – | – | – | 0 | 0 | 0 |
| Bud Neck | – | – | – | – | – | – | – | – | – | – | – | – | 0 | 0 | 0 |
| Bud Site | – | – | – | – | – | – | – | – | – | – | – | – | 0 | 0 | 0 |
| Cell Periphery | – | – | – | – | – | – | – | – | – | – | – | – | 0 | 0 | 0 |
| Cyto | – | – | – | – | – | – | – | – | – | – | – | – | – | – | – |
| Endoplasmic Reticulum | – | – | – | – | – | – | – | – | – | – | – | – | 0 | 0 | 0 |
| Endosome | – | – | – | – | – | – | – | – | – | – | – | – | 0 | 0 | 0 |
| Golgi | – | – | – | – | – | – | – | – | – | – | – | – | 0 | 0 | 0 |
| Mitochondria | – | – | – | – | – | – | – | – | – | – | – | – | 0 | 0 | 0 |
| Nuclear Periphery | – | – | – | – | – | – | – | – | – | – | – | – | 0 | 0 | 0 |
| Nuc | – | – | – | – | – | – | – | – | – | – | – | – | – | – | – |
| Nucleolus | – | – | – | – | – | – | – | – | – | – | – | – | 0 | 0 | 0 |
| Peroxisomes | – | – | – | – | – | – | – | – | – | – | – | – | 0 | 0 | 0 |
| SpindlePole | – | – | – | – | – | – | – | – | – | – | – | – | 0 | 0 | 0 |
| Vac | – | – | – | – | – | – | – | – | – | – | – | – | – | – | – |
| Cortical Patches | – | – | – | – | – | – | – | – | – | – | – | – | 0 | 0 | 0 |
| Cytoplasm | – | – | – | – | – | – | – | – | – | – | – | – | 0 | 0 | 0 |
| Nucleus | – | – | – | – | – | – | – | – | – | – | – | – | 0 | 0 | 0 |
| Vacuole | – | – | – | – | – | – | – | – | – | – | – | – | 1.0 | 2.1 | 0.7 |
External localization resources
Images






























Protein Concentration and Protein Localization Data
| R1 | R2 | R3 | ||||||||||||||||
|---|---|---|---|---|---|---|---|---|---|---|---|---|---|---|---|---|---|---|
| G1 Pre-START | G1 Post-START | S/G2 | Metaphase | Anaphase | Telophase | G1 Pre-START | G1 Post-START | S/G2 | Metaphase | Anaphase | Telophase | G1 Pre-START | G1 Post-START | S/G2 | Metaphase | Anaphase | Telophase | |
| Concentration | 0.1784 | 0.2094 | 0.1632 | -0.8148 | -0.5884 | -0.4428 | 3.1674 | 1.7193 | 1.4917 | 0.592 | 1.5215 | 1.8673 | 2.2883 | 3.0348 | 2.6494 | 2.2956 | 2.2523 | 2.7468 |
| Actin | 0.0406 | 0.0012 | 0.0144 | 0.0007 | 0.0035 | 0.0003 | 0.0522 | 0.0109 | 0.0008 | 0.003 | 0.1419 | 0.0105 | 0.0355 | 0.0031 | 0.01 | 0.0003 | 0.0015 | 0.0047 |
| Bud | 0.0021 | 0.0008 | 0.0004 | 0.0022 | 0.0001 | 0.0004 | 0.0028 | 0.0002 | 0.0158 | 0.0092 | 0.0008 | 0.0028 | 0.001 | 0.0003 | 0.002 | 0.0003 | 0.0006 | 0.001 |
| Bud Neck | 0.0033 | 0.0006 | 0.0024 | 0.0005 | 0.0002 | 0.0033 | 0.004 | 0.0001 | 0.0002 | 0 | 0.0018 | 0.0024 | 0.0054 | 0.0005 | 0.0005 | 0.0001 | 0.0221 | 0.0024 |
| Bud Periphery | 0.0037 | 0.0011 | 0.0006 | 0.0053 | 0.0001 | 0.0005 | 0.0033 | 0.0003 | 0.0026 | 0.0357 | 0.0015 | 0.004 | 0.0027 | 0.0005 | 0.0033 | 0.0003 | 0.0012 | 0.001 |
| Bud Site | 0.0218 | 0.0048 | 0.0042 | 0.0017 | 0.0001 | 0.0001 | 0.0131 | 0.0011 | 0.0058 | 0.0001 | 0.0014 | 0.0015 | 0.0055 | 0.005 | 0.0024 | 0.0001 | 0.0121 | 0.0038 |
| Cell Periphery | 0.0013 | 0.0003 | 0.0005 | 0.0002 | 0.0001 | 0.0001 | 0.0005 | 0.0001 | 0.0001 | 0.0001 | 0.0001 | 0.0004 | 0.0005 | 0.0002 | 0.0002 | 0 | 0.0006 | 0.0001 |
| Cytoplasm | 0.1173 | 0.2396 | 0.1915 | 0.1022 | 0.0204 | 0.1409 | 0.018 | 0.1839 | 0.1502 | 0.0521 | 0.0464 | 0.1217 | 0.0298 | 0.175 | 0.1354 | 0.0821 | 0.0454 | 0.1334 |
| Cytoplasmic Foci | 0.05 | 0.0077 | 0.0074 | 0.0142 | 0.0069 | 0.0109 | 0.0724 | 0.0044 | 0.0109 | 0.0013 | 0.0271 | 0.0131 | 0.0105 | 0.0056 | 0.0074 | 0.0038 | 0.0347 | 0.0058 |
| Eisosomes | 0.0041 | 0.0001 | 0.0005 | 0.0002 | 0.0004 | 0.0001 | 0.0006 | 0.0002 | 0.0001 | 0.0002 | 0.0006 | 0.0001 | 0.0006 | 0.0002 | 0.0002 | 0 | 0.0004 | 0.0001 |
| Endoplasmic Reticulum | 0.0248 | 0.0057 | 0.0025 | 0.0009 | 0.0003 | 0.0016 | 0.0193 | 0.0022 | 0.0014 | 0.0008 | 0.0007 | 0.0036 | 0.0049 | 0.0012 | 0.0031 | 0.0014 | 0.0003 | 0.0007 |
| Endosome | 0.0512 | 0.021 | 0.0039 | 0.0019 | 0.0057 | 0.0033 | 0.0672 | 0.0009 | 0.0009 | 0.0004 | 0.0069 | 0.0099 | 0.0109 | 0.0013 | 0.0029 | 0.0037 | 0.0016 | 0.0026 |
| Golgi | 0.0227 | 0.003 | 0.003 | 0.0002 | 0.0107 | 0.0002 | 0.0237 | 0.0009 | 0.0002 | 0.0001 | 0.0121 | 0.0025 | 0.0042 | 0.0003 | 0.0009 | 0.0001 | 0.0002 | 0.0005 |
| Lipid Particles | 0.0378 | 0.0013 | 0.0043 | 0.0006 | 0.0102 | 0.0029 | 0.0726 | 0.0011 | 0.0003 | 0.0001 | 0.0148 | 0.0007 | 0.0096 | 0.0007 | 0.0008 | 0.0004 | 0.001 | 0.0007 |
| Mitochondria | 0.0233 | 0.0013 | 0.0091 | 0.0003 | 0.0144 | 0.0003 | 0.0118 | 0.0013 | 0.0007 | 0.007 | 0.0008 | 0.0027 | 0.0027 | 0.0004 | 0.0006 | 0.0003 | 0.0004 | 0.0009 |
| None | 0.5013 | 0.563 | 0.6547 | 0.8643 | 0.9211 | 0.7349 | 0.4595 | 0.7806 | 0.7635 | 0.8724 | 0.7042 | 0.8124 | 0.831 | 0.7733 | 0.7965 | 0.8874 | 0.8685 | 0.7931 |
| Nuclear Periphery | 0.024 | 0.0036 | 0.0018 | 0.0004 | 0.0002 | 0.0025 | 0.0501 | 0.001 | 0.0014 | 0.0099 | 0.0016 | 0.0018 | 0.0117 | 0.0009 | 0.0024 | 0.0027 | 0.0003 | 0.0011 |
| Nucleolus | 0.0036 | 0.0015 | 0.0013 | 0.0002 | 0.0001 | 0.0014 | 0.0045 | 0.0001 | 0.0009 | 0.0005 | 0.0002 | 0.001 | 0.0013 | 0.0006 | 0.0007 | 0.0003 | 0.0007 | 0.0015 |
| Nucleus | 0.0151 | 0.13 | 0.0819 | 0.0006 | 0.0002 | 0.0835 | 0.0152 | 0.0039 | 0.0393 | 0.0035 | 0.0003 | 0.0038 | 0.0043 | 0.0262 | 0.021 | 0.0072 | 0.0008 | 0.0421 |
| Peroxisomes | 0.0244 | 0.0002 | 0.0106 | 0.0008 | 0.0041 | 0.0004 | 0.0737 | 0.0055 | 0.0011 | 0.0004 | 0.0233 | 0.0005 | 0.0141 | 0.0009 | 0.0032 | 0.0001 | 0.0054 | 0.0005 |
| Punctate Nuclear | 0.0149 | 0.007 | 0.0019 | 0.0015 | 0.0005 | 0.0101 | 0.0248 | 0.0009 | 0.003 | 0.0013 | 0.0131 | 0.0028 | 0.0117 | 0.0028 | 0.0049 | 0.0084 | 0.0015 | 0.0024 |
| Vacuole | 0.0102 | 0.0055 | 0.0029 | 0.0008 | 0.0003 | 0.0021 | 0.0052 | 0.0004 | 0.0007 | 0.0006 | 0.0002 | 0.0011 | 0.0012 | 0.001 | 0.0014 | 0.0007 | 0.0004 | 0.0012 |
| Vacuole Periphery | 0.0024 | 0.0005 | 0.0004 | 0.0001 | 0.0003 | 0.0002 | 0.0053 | 0.0001 | 0.0001 | 0.0013 | 0.0001 | 0.0007 | 0.001 | 0.0001 | 0.0002 | 0.0001 | 0.0001 | 0.0003 |
Sequencing Data
| R1 | R2 | |||||||||
|---|---|---|---|---|---|---|---|---|---|---|
| G1 Post-START | S/G2 | Metaphase | Anaphase | Telophase | G1 Post-START | S/G2 | Metaphase | Anaphase | Telophase | |
| Gene Expression | 91.2767 | 24.0873 | 10.2775 | 25.9327 | 113.1039 | 67.9989 | 21.4626 | 11.0955 | 17.1608 | 130.7192 |
| Translational Efficiency | 1.0578 | 0.7939 | 0.5245 | 0.4718 | 0.9077 | 1.5939 | 0.8361 | 0.7748 | 0.5279 | 0.728 |
Hit Data
| Dataset | Hit |
|---|---|
| Protein Concentration | ✔ |
| Protein Localization | ✘ |
| Gene Expression | ✔ |
| Translational Efficiency | ✔ |
Endocytosis
| Temp | Actin Patch (Sac6-tdTomato) | Cortical Patch (Sla1-GFP) | Late Endosome (Snf7-GFP) | Vacuole (Vph1-GFP) |
|---|---|---|---|---|
| 37℃ | ||||
| RT |
Cell Cycle Omics
CYCLoPs (Cln2-GFP)
| Gene / Allele | Actin Patch (Sac6-tdTomato) | Cortical Patch (Sla1-GFP) | Late Endosome (Snf7-GFP) | Vacuole (Sac6-tdTomato) |
|---|
| Gene | Images |
|---|
| Gene | Images |
|---|
Images are not yet available
Images are not yet available